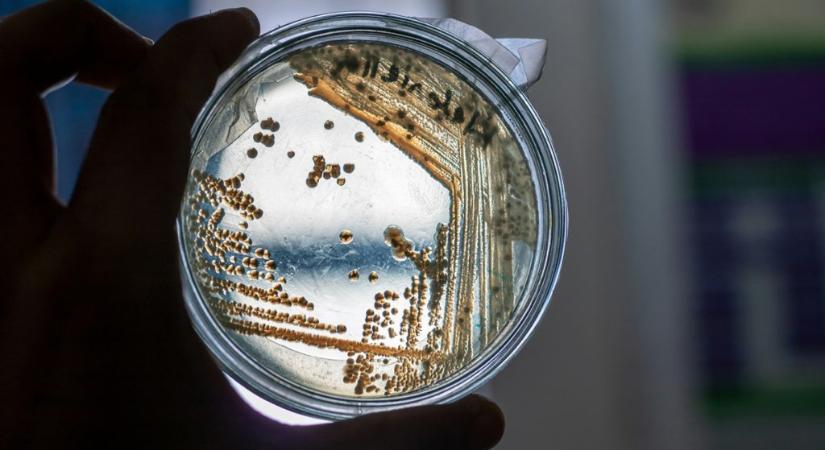
Meglepő felfedezés: egy hétköznapi szer segíthet legyőzni a szuperbaktériumokat

Meglepő felfedezés: egy hétköznapi szer segíthet legyőzni a szuperbaktériumokat
Egyszerű, olcsó és valószínűleg ott lapul a te konyhádban is – mégis új reményt jelenthet az orvostudománynak. Kutatók szerint ez a mindennapi szer képes lehet felvenni a harcot a legellenállóbb kórokozókkal is. Meglepő felfedezés: egy hétköznapi szer segíthet legyőzni a szuperbaktériumokat
Hamarosan átirányítunk a teljes cikkhez → Well and Fit